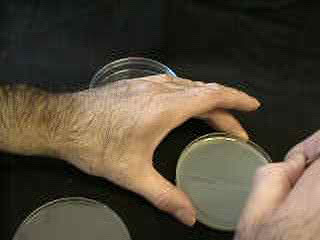

Comment obtenir des racines bien droites afin d'analyser la réaction gravitropique?
Si on sème des graines sur une surface nutrutive, la croissance se fera de manière désordonnée dans un premier temps. Il est nécessaire d'obtenir des racines vien droites pour expérimenter. Pour cela, suivre le protocole :
- imbiber les graines de Radis pendant 2 à 3 heures environ
- placer les graines sur une feuille de papier essuie-tout imbibé d'eau,
- rouler le papier,
- entourer le rouleau dans un sac en plastique,
- et le suspendre verticalement.
 |
 |
Les graines sont placées sur une feuille de papier absorbant
imbibé d'eau. |
La feuille est roulée et suspendue verticalement dans un
sac en plastique. |
Après le temps nécessaire à la germination (entre 2 à 3 jours) : Quelque soit la position d'origine de la radicule, toutes les racines ont poussé vers le bas et sont droites et verticales.
 |
 |
Le papier est déroulé.
Les graines ont germé et les racines sont majoritairement
orientées verticalement. |
|
- couler 1 cm de gélose à 2 % dans des boîtes de Pétri,
- puis couper la gélose et en enlever la moitié.
|
 |
Deux étapes de la fabrication
de demi boîtes de gelose. Voir une vidéo (1 Mo). |
|
| Pour voir cette manipulation en vidéo ---------------> |
|---|
- Sur la surface de section de la gélose laissée dans la boîte, faire quelques trous verticaux (de la longeur des racines à l'aide d'une pince courbe ou d'un fil de fer recourbé),
- planter les germinations dans ces orifices,
- fermer les boites et placez les sur leur tranche.
 |
 |
| La section de la gélose placée horizontalement est percée de trous dans lesquels les germinations seront déposées. Voir une vidéo (924 Ko) | |
| Pour voir cette manipulation en vidéo ---------------> |
|---|
Placer les boites pour que les racines soient en position verticale ou horizontale.
 |
 |
La même boîte expérimentale.
Les racines ont été plantées verticalement,
puis la boîte posée sur sa tranche est tournée
de 90° de manière à soumettre latéralement
les racines à la gravité. |
|
Remarque : si l'on a préparé les boîtes à l'avance et si l'on a conservé les germinations dans le papier humide, le contact avec l'air ne dure que quelques secondes et les racines ne sont pas lésées
Pour observer avec précision la réaction gravitropique, il est nécessaire de :
- bien fermer les boîtes de Pétri pour éviter la déshydratation de la gelose,
- placer les boîtes sur la tranche et bien les fixer de manière que les racines restent bien horizontales,
- placer les boîtes de préférence à l'obscurité ou en lumière atténuée pour éviter une réaction phototropique supplémentaire.
La réaction gravitropique est relativement lente. La première indication d'une courbure apparaît au bout d'une heure et devient bien observable après 2 heures d'exposition. Si les boîtes sont gardées bien posées sur la tranche, les réactions sont remarquables après 8 heures ou 24 heures.
 |
 |
 |
3 étapes des réactions
gravitropiques simultanées de 5 plantules. Les racines ont
une réaction gravitropique positive alors que les hypocotyles
ont une réaction gravitropique négative. |
||
| Pour voir ces mouvements en vidéo ---------------> |
|---|
 |
 |
 |
3 étapes des réactions
gravitropiques d'une plantule. la flèche indique la position de l'apex au temps 0 |
||
| Pour voir ce mouvement en vidéo ---------------> |
|---|